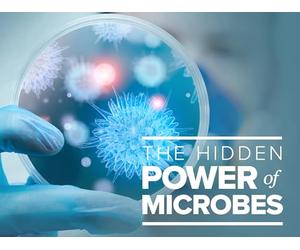
The Human Microbiome

The Human Microbiome
£2.49
Amazon-marketplace.co.uk
Delivery from £3.99

The Human Microbiota and Microbiome: 25 (Advances in Molecular and Cellular Microbiology)
£42.14
Amazon-marketplace.co.uk
Delivery from £2.80

Dietary Fiber: Essential To The Human Microbiome and Health: Dietary Fiber: 1
£10.24
amazon.co.uk
Free Delivery

The Human Superorganism: How the Microbiome Is Revolutionizing the Pursuit of a Healthy Life
£27.37
Amazon-marketplace.co.uk
Free Delivery


The Human Microbiome in Health and Disease: An Introduction
£52.42
Amazon-marketplace.co.uk
Free Delivery

Strange Biology Facts That Sound Fake: Mind-Blowing Facts About Cells, DNA, the Human Microbiome, Regeneration, and Hidden Biological Processes Inside ... Body (100 Weird Facts About the Human Body)
£10.52
amazon.co.uk
Free Delivery

The Human Microbiome
£1.89
Amazon-marketplace.co.uk
Delivery from £3.99

The 2027-2032 World Outlook for Human Microbiome Therapeutics
£890.00
amazon.co.uk
Free Delivery

The Gut-Brain Paradox : Improve Your Mood, Clear Brain Fog, and Reverse Disease by Healing Your Microbiome
£26.60
Whsmith.co.uk
Free Delivery

MACROBIOME: How the Human Microbiome Reflects Our Health and Relationship with Nature
£14.99
amazon.co.uk
Free Delivery

Gut Feelings : The Microbiome and Our Health
£21.85
Whsmith.co.uk
Delivery from £3.99

The 2027-2032 World Outlook for Human Microbiome Studies and Treatments for Acute Diarrhea
£890.00
amazon.co.uk
Free Delivery


Healthy Food for Healthy Humans: How the Food Microbiome Contributes to Human Health
£87.99
amazon.co.uk
Free Delivery


Fascinating Facts About Human Skin - Book 2: Microbiome, Skin Cells, Nerves and the Secrets of Our Body’s
£7.99
amazon.co.uk
Delivery from £2.99

Endophytes: The Silent Architects of Plant and Human Well-being
£170.99
Whsmith.co.uk
Free Delivery

Gateway of Biology: The Oral Microbiome, Saliva, and the Hidden Gatekeepers of Human Health
£18.20
amazon.co.uk
Free Delivery

The Gut Microbiome in Health and Disease : A Textbook
£94.99
Whsmith.co.uk
Free Delivery

The Microbiome and Human Health: A new Era of Research
£10.45
amazon.co.uk
Free Delivery

Gut-brain Connection, Myth Or Reality?: Role Of The Microbiome In Health And Diseases
£109.25
Whsmith.co.uk
Free Delivery

Invivo Bio.Me IB+ (60 Capsules / 2 Months Supply) - 3 Billion CFU Probiotic Capsule Supplement - Gut Microbiome Supplement with Unique Combination of 2 Healthy Bacteria for the Gut Microbiome (60)
£31.99
21.33 GBP/100.0 g
Amazon-marketplace.co.uk
Free Delivery

The Gut Microbiome : Exploring the Connection between Microbes, Diet, and Health
£55.00
Whsmith.co.uk
Free Delivery

Multibiotic - Together Health - 45 Farm-Grown Fermented Foods - Multi Bacterial Strains with 13 Billion CFU - Vegan Friendly - Made in The UK - Pack of 6-180 Capsules
£72.63
Amazon-marketplace.co.uk
Free Delivery

Human-Gut Microbiome : Establishment and Interactions
£109.25
Whsmith.co.uk
Free Delivery

Akkermansia muciniphila 20 mg - 30 Vegan Capsules | 30-Day Supply - Gut Microbiome Support & Metabolic Support - Apollo's Hegemony
£20.60
0.69 GBP/1.0 count
Amazon-marketplace.co.uk
Free Delivery

The Environmental Microbiome
£161.50
Whsmith.co.uk
Free Delivery

maxxidigest+ for Dogs | Probiotic & Digestive Enzyme Powder | Supports Gut Health, Stool Quality & Sensitive Digestion | Daily Digestive & Microbiome Support | NON-GMO | 200g
£35.68
178.4 GBP/1.0 kg
Amazon-marketplace.co.uk
Free Delivery

Diet and the Microbiome
£161.50
Whsmith.co.uk
Free Delivery

OMNi BiOTiC HETOX | Relief for the Liver - From the Gut | Probiotic Powder | Particularly Easy to Take Due to Practical Sachets | 30 Sachets | Vegan | Glutenfree | Lactose-free | Halal | For daily use
£82.60
45.89 GBP/100.0 g
amazon.co.uk
Free Delivery

The Gut Microbiome : Bench to Table
£48.44
Whsmith.co.uk
Free Delivery

Invivo Bio.Me Femme V - 3 Billion CFU Probiotic Capsule Supplement for Women - Vaginal Probiotic Supplement with 5 Unique Strains of Healthy Bacteria for Microbiome - 60 Capsules
£39.13
26.09 GBP/100.0 g
Amazon-marketplace.co.uk
Free Delivery

The Secret Body : How the New Science of the Human Body Is Changing the Way We Live
£9.49
Whsmith.co.uk
Delivery from £3.99

Invivo Bio.Me Femme V - 3 Billion CFU Probiotic Capsule Supplement for Women - Vaginal Probiotic Supplement with 5 Unique Strains of Healthy Bacteria for Microbiome - 30 Capsules
£31.50
1.05 GBP/1.0 count
Amazon-marketplace.co.uk
Free Delivery

Allergic to Life : How the Human Body Rejects the Modern World
£37.99
Whsmith.co.uk
Free Delivery

The Human Biome and Human Behaviour : A Biopsychological Perspective
£43.69
Whsmith.co.uk
Free Delivery

Super Gut: A Four-Week Plan to Reprogram Your Microbiome, Restore Health and Lose Weight
£7.59
rackhams.com
Free Delivery

The Microbiome, Gut Health and Oriental Medicine : An Integrated Approach
£23.74
Whsmith.co.uk
Delivery from £3.99

Beekman 1802 Goat Milk Soap with Ice Mint and Eucalyptus Fragranced 100ml Clean, Nourishes and Moisturises, Certified as Microbiome Friendly, Non-Irritating, Suitable for Sensitive
£18.61
187.56 GBP/1.0 kg
Amazon-marketplace.co.uk
Free Delivery
- 1
- 2
- next page
🤖 Ask ChatGPT
🛍️ What are the most important purchase criteria?
💰 Tell me the best deals!
📋 Create a short summary!
Informations about "the human microbiome"
With Pricehunter, you can compare buy prices online in order to find the offer that most fulfills your requirements "the human microbiome".
Based on your search criteria "the human microbiome", our price search engine found the lowest prices in 47 categories.
About "the human microbiome"
- Lowest prices found in 6 different mail order companies, including Amazon-marketplace.co.uk, Whsmith.co.uk, amazon.co.uk and rackhams.com.
- After having chosen your brands you may also choose the delivery company. 8 delivery producers are available Princeton University Press, Taylor & Francis Group, Oxford University Press and createspace being the most popular.
- 8 different producers offer the product - Princeton University Press, Taylor & Francis Group, Oxford University Press and createspace, that you were looking for.
- Furthermore, other costumers also looked for the following product .
- With Pricehunter you are also spoilt for choice for colours. You can select your favourite from 0 coloration. The article is most commonly ordered in the colour .
Don't forget your voucher code:
Report Illegal Concerns
You are about to report a violation based on the EU Digital Services Act (DSA).